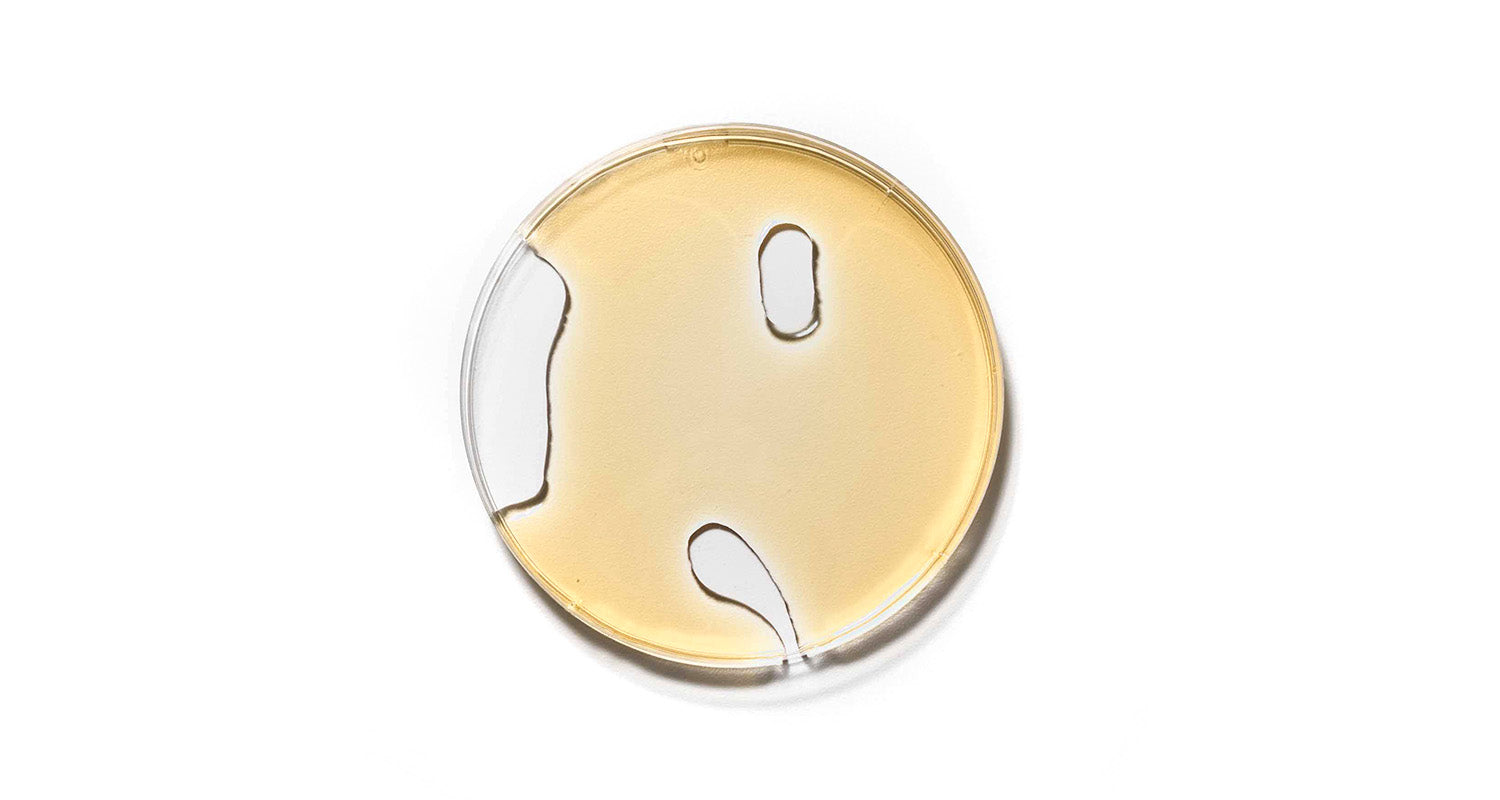
Olive tree leaves

Glossary ingredients
Discover the high-quality, naturally sourced and vegan ingredients behind our formulas and learn about their properties and benefits.














Discover the high-quality, naturally sourced and vegan ingredients behind our formulas and learn about their properties and benefits.